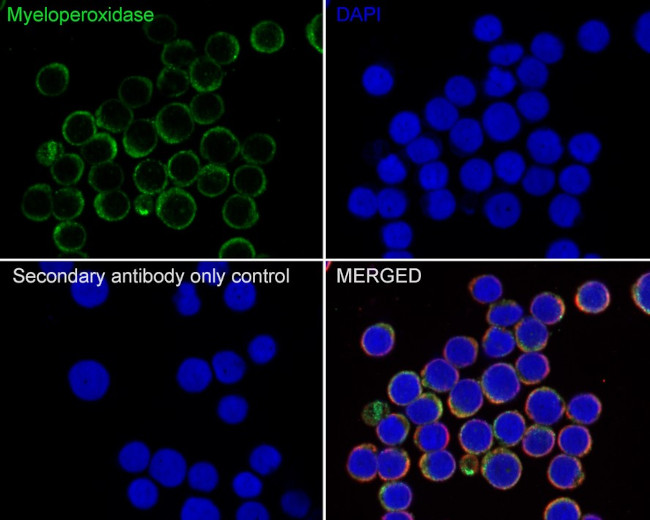
Myeloperoxidase Antibody in Immunocytochemistry (ICC/IF)

Search
Invitrogen
Myeloperoxidase Recombinant Rabbit Monoclonal Antibody (PD00-20)
{{$productOrderCtrl.translations['antibody.pdp.commerceCard.promotion.promotions']}}
{{$productOrderCtrl.translations['antibody.pdp.commerceCard.promotion.viewpromo']}}
{{$productOrderCtrl.translations['antibody.pdp.commerceCard.promotion.promocode']}}: {{promo.promoCode}} {{promo.promoTitle}} {{promo.promoDescription}}. {{$productOrderCtrl.translations['antibody.pdp.commerceCard.promotion.learnmore']}}
图: 1 / 6
Myeloperoxidase Antibody (MA5-50687) in ICC/IF






Please note: We are reviewing Western blot images included in the antibody testing data in our catalog, including those provided by third parties. Unless expressly labeled or annotated as “raw-unedited”, Western blot images included in the antibody testing data in our catalog may have been edited, optimized or otherwise adjusted for presentation.
产品信息
MA5-50687
种属反应
宿主/亚型
Expression System
分类
类型
克隆号
抗原
偶联物
形式
浓度
规格
纯化类型
保存液
内含物
保存条件
运输条件
RRID
产品详细信息
Positive control: Human tonsil tissue, human lung tissue, human liver tissue, human spleen tissue.
Predicted band size: 84 kDa
Subcellular Location: Lysosome.
靶标信息
Myeloperoxidase (MPO) is a heme protein that is synthesized during myeloid differentiation and is a major component of neutrophil azurophilic granules. It is produced as a single chain precursor and subsequently cleaved into a light and heavy chain. The mature MPO is a tetramer composed of 2 light chains and 2 heavy chains. This enzyme is responsible for producing hypohalous acids that are central to the microbicidal activity of neutrophils. Diseases that are associated with MPO include Myeloperoxidase Deficiency and Alzheimer's Disease, Familial, 1.
仅用于科研。不用于诊断过程。未经明确授权不得转售。